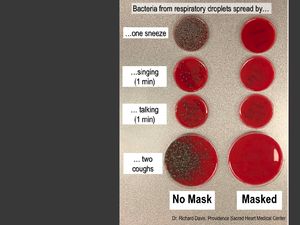
Eksperimen Viral Ini Buktikan Masker Paling Ampuh Halangi Mikroba

detikHealthJumat, 10 Jul 2020 08:50 WIB
detikHealthJumat, 10 Jul 2020 08:50 WIB
Mikrodroplet Bisa Tularkan Corona, Samakah Artinya dengan Airborne?
Virus Corona bisa menyebar lewat udara di ruangan tertutup karena microdroplet bisa melayang-layang dalam waktu lama. Samakah maksudnya dengan airborne?